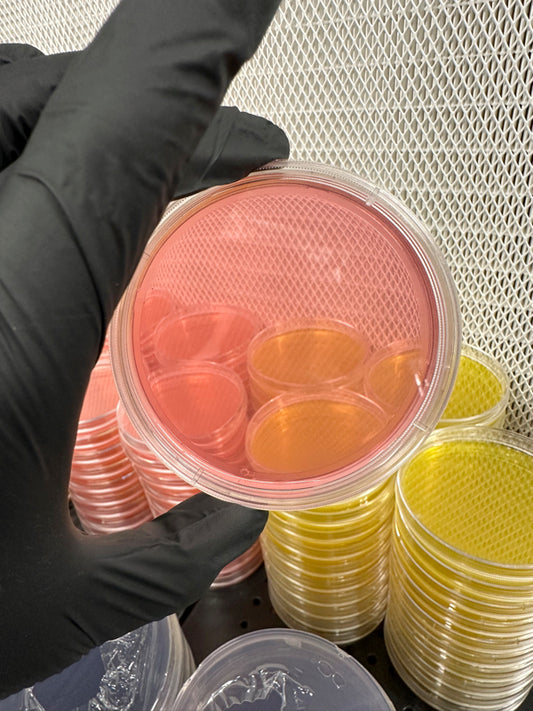

-
AgotadoSlant Rack
Proveedor:Mycology SimplifiedPrecio habitual $15.99Precio habitualPrecio de oferta $15.99Agotado -
Autoclavable/Reusable PP5 Petri Dishes
Proveedor:Microppose5.0 / 5.0
(8) 8 reseñas totales
Precio habitual $15.00Precio habitualPrecio de oferta $15.00 -
Agar Agar Powder – 1 Pound Bulk Bag for Fungi Culturing
Proveedor:Mycologysimplified5.0 / 5.0
(4) 4 reseñas totales
Precio habitual $25.00Precio habitual$29.00Precio de oferta $25.00Agotado -
Pre Poured Sorghum Yeast Agar for Fungi Culturing – Sterile, High-Quality Sorghum Yeast Agar
Proveedor:Mycologysimplified4.93 / 5.0
(58) 58 reseñas totales
Precio habitual A partir de $7.99Precio habitualPrecio de oferta A partir de $7.99 -
Rubber Case for AirPods®
Proveedor:MycologysimplifiedPrecio habitual $20.00Precio habitualPrecio de oferta $20.00 -
Unisex Tank Top
Proveedor:MycologysimplifiedPrecio habitual A partir de $30.00Precio habitualPrecio de oferta A partir de $30.00 -
Snapback Hat
Proveedor:Mycologysimplified5.0 / 5.0
(1) 1 reseñas totales
Precio habitual $30.00Precio habitualPrecio de oferta $30.00 -
Microppose 1.5" Tub Filters For Mushroom Cultivation
Proveedor:MycologysimplifiedPrecio habitual $1.25Precio habitualPrecio de oferta $1.25 -
Botellas de medios
Proveedor:Mycologysimplified5.0 / 5.0
(5) 5 reseñas totales
Precio habitual A partir de $12.99Precio habitualPrecio de oferta A partir de $12.99 -
Polvo de agar premezclado
Proveedor:Mycologysimplified4.88 / 5.0
(8) 8 reseñas totales
Precio habitual A partir de $7.99Precio habitualPrecio de oferta A partir de $7.99 -
Engendro de grano de champiñones de maíz de 5 libras
Proveedor:Mycologysimplified5.0 / 5.0
(11) 11 reseñas totales
Precio habitual $15.00Precio habitualPrecio de oferta $15.00 -
Engendro de grano de champiñones de maíz de 3 libras
Proveedor:Mycologysimplified4.73 / 5.0
(15) 15 reseñas totales
Precio habitual $10.00Precio habitualPrecio de oferta $10.00 -
Engendro de grano de champiñón estéril Milo / Sorgo de 5 libras
Proveedor:Mycology Simplified4.71 / 5.0
(14) 14 reseñas totales
Precio habitual $15.00Precio habitualPrecio de oferta $15.00 -
Filtros de tina Microppose de 3 "para el cultivo de hongos
Proveedor:Mycologysimplified5.0 / 5.0
(1) 1 reseñas totales
Precio habitual $2.25Precio habitualPrecio de oferta $2.25 -
Filtros de tina Microppose de 2 "para el cultivo de hongos
Proveedor:Microppose5.0 / 5.0
(4) 4 reseñas totales
Precio habitual $1.50Precio habitualPrecio de oferta $1.50 -
Kit de recambio de caja de zapatos de 12 qt | Sustrato y grano de hongos
Proveedor:Mycologysimplified4.7 / 5.0
(27) 27 reseñas totales
Precio habitual A partir de $19.99Precio habitualPrecio de oferta A partir de $19.99 -
Kit de recambio de caja de zapatos de 6qt | Combo De Champiñones Y Granos
Proveedor:Mycologysimplified4.7 / 5.0
(27) 27 reseñas totales
Precio habitual A partir de $15.99Precio habitual$19.99Precio de oferta A partir de $15.99Oferta -
Sustrato Masters Mix
Proveedor:Mycologysimplified5.0 / 5.0
(8) 8 reseñas totales
Precio habitual A partir de $12.99Precio habitualPrecio de oferta A partir de $12.99 -
Tarjeta Regalo Micología Simplificada
Proveedor:Mycologysimplified5.0 / 5.0
(1) 1 reseñas totales
Precio habitual A partir de $10.00Precio habitualPrecio de oferta A partir de $10.00
Featured collection
-
Engendro de grano de champiñones de maíz de 3 libras
Precio habitual $10.00Precio habitualPrecio de oferta $10.00 -
Agar iniciador de esporas bajo en nutrientes
Precio habitual A partir de $7.99Precio habitualPrecio de oferta A partir de $7.99 -
Peptona de levadura de malta (MYPA)
Precio habitual A partir de $7.99Precio habitualPrecio de oferta A partir de $7.99 -
Engendro de grano de champiñón estéril Milo / Sorgo de 5 libras
Precio habitual $15.00Precio habitualPrecio de oferta $15.00